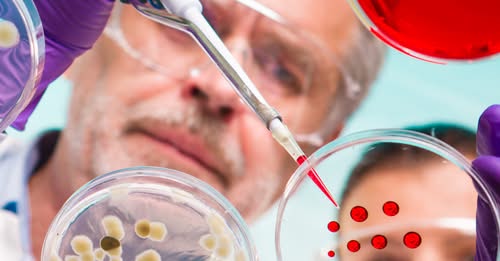

Orbán Viktor: A háború nem sakkjátszma!
Orbán Viktor a háború borzalmairól – Háborúellenes Gyűlés, Nyíregyháza.
#haboruellenesgyules #nyiregyhaza #OrbanViktor #ellenzek #hirtv
Orbán Viktor: Az európai vezetők háborút akarnak
Orbán Viktor nyugtalanító tendenciákat lát a Nyugaton erősödő háborúpárti nézetekkel kapcsolatban.
Orbán Viktor: A háború nem sakkjátszma!
Orbán Viktor a háború borzalmairól – Háborúellenes Gyűlés, Nyíregyháza.
#haboruellenesgyules #nyiregyhaza #OrbanViktor #ellenzek #hirtv
Beolvasott nekik rendesen!
Kattints a részletekért: https://tenyek.hu/politika/2025/11/menczer-tamas-beolvasott-a-tiszas-megszoritocsomagot-izzadva-vedo-baloldali-mediumoknak

 Amíg Orbán Viktor a kormányfő, az idősek biztonságban vannak.
Amíg Orbán Viktor a kormányfő, az idősek biztonságban vannak.
👉 Részletek a cikkben: https://tenyek.hu/politika/2025/11/amig-orban-viktor-a-kormanyfo-az-idosek-biztonsagban-erezhetik-magukat-video…

 Megszólalt az ukrán toborzótisztek által brutálisan agyonvert Sebestyén József testvére.
Megszólalt az ukrán toborzótisztek által brutálisan agyonvert Sebestyén József testvére.
👉 Részletek+videó: https://tenyek.hu/politika/2025/11/orban-viktor-magyarorszag-tovabbra-is-a-beke-partjan

 Nyíregyházán már nem csak kiabálás volt...
Nyíregyházán már nem csak kiabálás volt...
👉 Részletek a cikkben: https://tenyek.hu/politika/2025/11/nyiregyhazan-is-lecsapott-a-tiszas-gyuloletkommando

 ️Új részletek kerültek elő a Tisza csomagjáról… és ha igazak, annak a gyerekes családok ihatják meg a levét.
️Új részletek kerültek elő a Tisza csomagjáról… és ha igazak, annak a gyerekes családok ihatják meg a levét.
👉 Részletek a cikkben: https://tenyek.hu/politika/2025/11/koncz-zsofia-a-tisza-megszorito-…

 A közvélemény-kutatások is kezdenek igazolni valamit, ami sokaknak kellemetlen lehet...
A közvélemény-kutatások is kezdenek igazolni valamit, ami sokaknak kellemetlen lehet...
👉 Részletek a cikkben: https://tenyek.hu/politika/2025/11/deak-daniel-orban-viktort-erositi-hogy-magyar-peter-…


Tényi István: A túlszámlázásokról, kétes kifizetésekről és felesleges luxuskiadásokról elhíresült Budapest Brand-botrány ügyében keletkezett feljelentés.

Ha az intelligenciára gondolunk, az emberi agyat képzeljük el: egy központot, ahol…